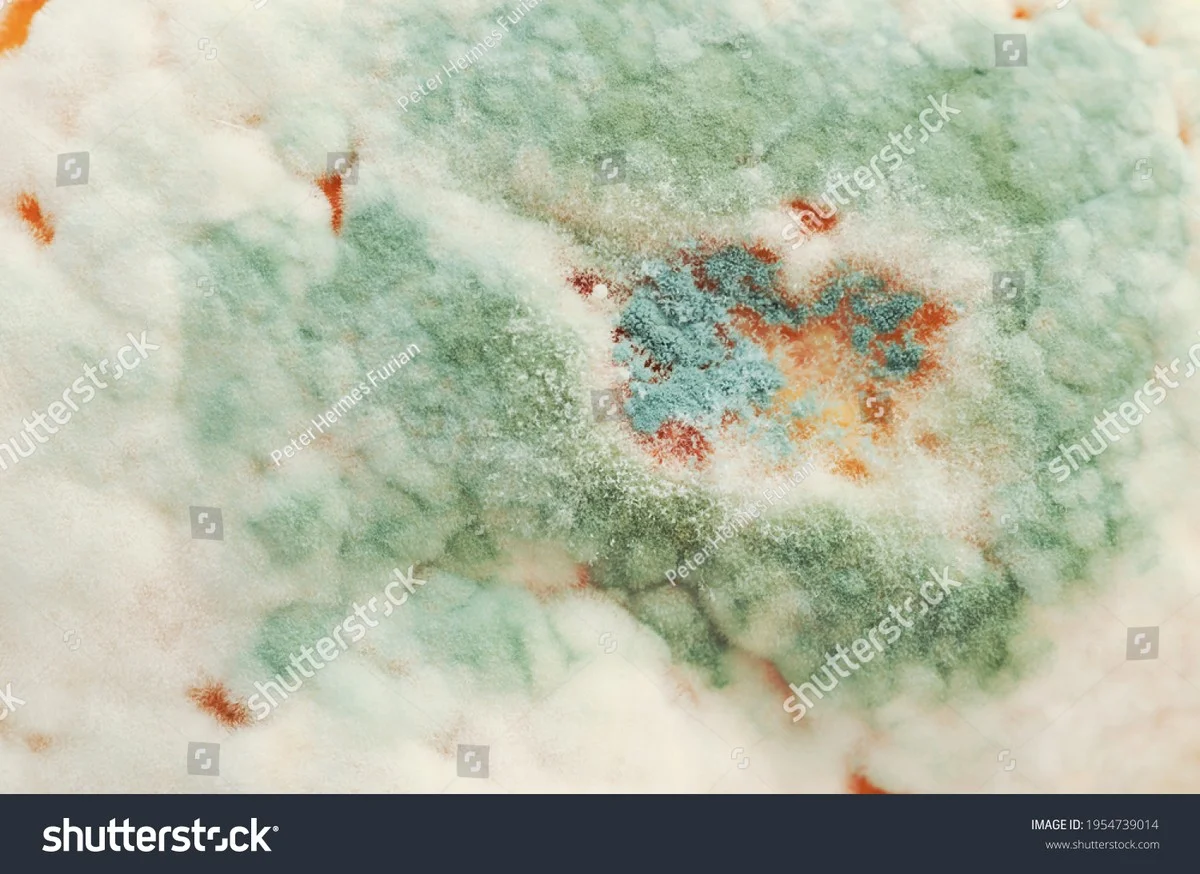
Citrónová kůra v sprše: jak se zbavit plísní bez chemie

Bobkový list do mouky: stará trična proti hmyzu, která funguje dodnes
Otevřeš zásuvku s moukou a najdeš tam malinké černé tečky nebo dokonce larvy. Frustrace, ztracené koruny a toxické spreje — zbytečné. Teď je ideální čas jednat: teplé, vlhké léto v Česku molům nahrává a velké balení mouky z Lidlu nebo Kauflandu se může zkazit za pár týdnů. Všiml jsem si, že jednoduché osvědčené triky z … Číst dál